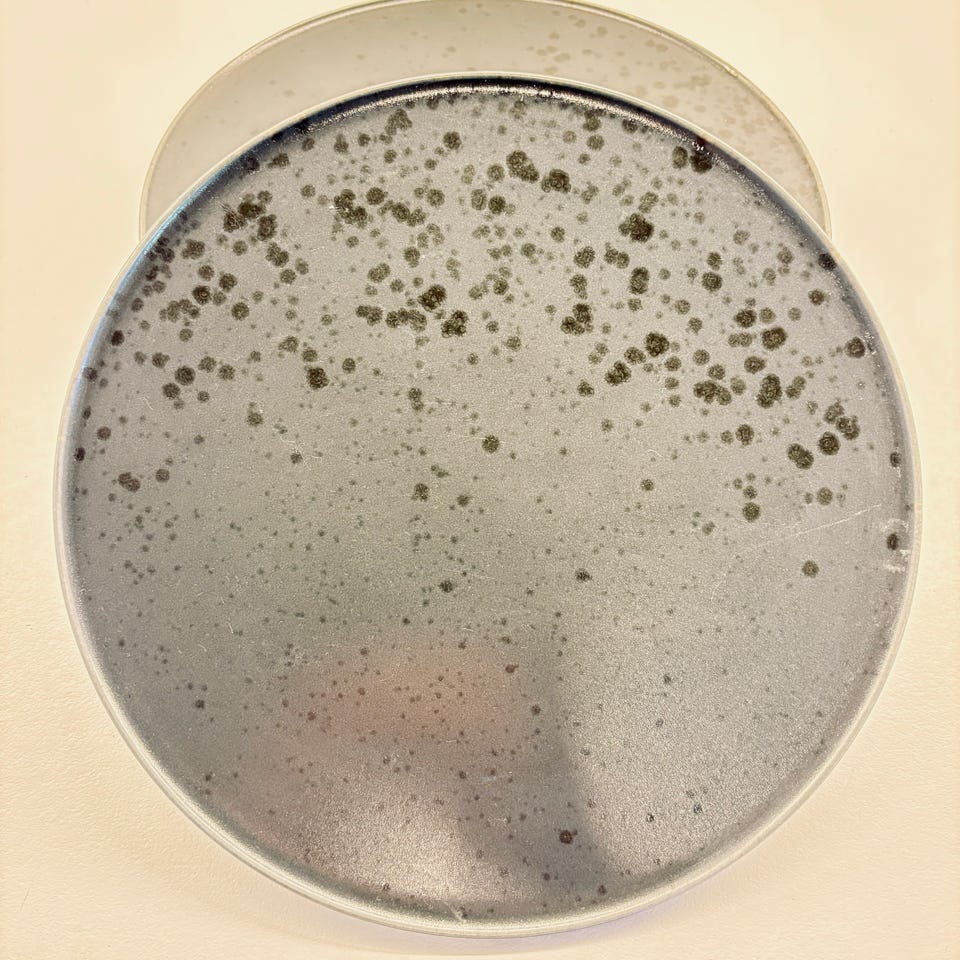
Galleribillede

Billedgalleri
(1/4)
Seks stentøj- tallerkener
Til salg
150 kr.
Bed sælgeren om at sende med Fiks færdig! Det er trygt, hurtigt, og varen vil blive sendt til dig. Læs mere
Varebeskrivelse
Stand: Brugt - men i god stand
Stentøj-tallerkener i gråt stentøj med prikket mønster på oversiden. Tallerkenerne er runde med let markeret kant og glaseret overflade. Undersiden er mørkere med cirkulære ringe i lysere nuance. Egner sig til daglig brug som middags- eller frokosttallerkener og kan anvendes i køkken og spisestue som ensartet stel. Kan sendes mod betaling og afhentes på adressen.
Bemærk: Knappen til at vise den fulde beskrivelse har kun en visuel effekt.
Brugerprofil

Du skal være logget ind for at se brugerprofiler og sende beskeder.
Log indAnnoncens metadata
Sidst redigeret: 21.4.2026 kl. 20:18 ・ Annonce-ID: 20734164